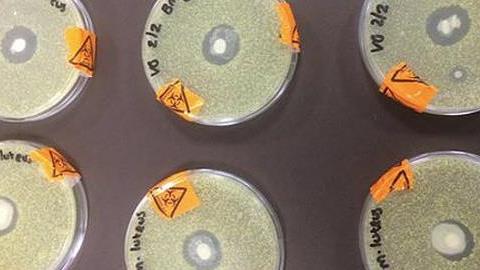
Ένα απλό πείραμα αποδεικνύει πώς το μητρικό γάλα καταπολεμά τους ιούς!

Αυτές ακριβώς τις σκέψεις έκανα κι εγώ τις τελευταίες μέρες, λίγο πριν σταματήσω να θηλάζω, όταν επρόκειτο να επιστρέψω στην δουλειά, έπειτα από την άδεια λοχείας. Η αγωνία μου πολλαπλή: Τι θα έκανε το μωρό μου όλες αυτές τις ώρες που θα βρισκόμουν μακριά του; Ποιο θα ήταν το κατάλληλο άτομο για να μείνει μαζί του; Τι θα έτρωγε; Ποιο θα ήταν το ιδανικό γάλα, για να συνεχίσει μετά το δικό μου; Εξάλλου, τι χρειάζεται ένα μωρό για να είναι ευτυχισμένο; Μια τρυφερή αγκαλιά που θα το κάνει να νιώθει ασφάλεια και αγάπη, σωστή διατροφή και καθαριότητα. Και ήταν δική μου ευθύνη να φροντίσω για όλα αυτά.
Και χαμένη καθώς ήμουν στις σκέψεις αυτές, τυχαία έπεσα πάνω στο παρακάτω βίντεο που με έκανε να σκεφτώ ακόμα περισσότερα. Όποια απόφαση κι αν έπαιρνα για το μωρό μου, για να είναι σωστή, θα έπρεπε να είναι κατάλληλη για την ηλικία του.
Κατάλληλο για την ηλικία του, λοιπόν, στους μόλις 7 μήνες της ζωής του, ήταν, όταν εγώ θα επέστρεφα στη δουλειά, εκείνο να παραμένει στο σπίτι μας, στο περιβάλλον του, με τον αμέσως επόμενο καλύτερο άνθρωπο για να του δώσει φροντίδα και αγάπη, έπειτα από εμένα: Τη μαμά μου. Την λατρεμένη του γιαγιά, δηλαδή, που έχω την τύχη να έχω ακμαία και πρόθυμη στο πλευρό μου.
Κατάλληλο για την ηλικία του, αναφορικά με την διατροφή του, ήταν, αφού εγώ δεν θα θήλαζα πια, να τρέφεται με ένα γάλα που θα αποτελούσε το αμέσως καλύτερο μετά το δικό μου. Έπειτα από εκτενή συζήτηση με την παιδίατρό μας, καταλήξαμε ότι αυτό θα ήταν ένα γάλα ειδικά σχεδιασμένο για τις ανάγκες ενός μωρού, εμπλουτισμένο με «καλά» λιπαρά που δεν θα αυξήσουν υπερβολικά το βάρος του, καθώς και με σίδηρο και βιταμίνη D.
Το έψαξα και μόνη μου, αναζητώντας επιστημονική στοιχεία, και διαπίστωσα ότι καθώς ο οργανισμός του παιδιού έχει ανάγκη από σημαντικά μεταλλικά στοιχεία, όπως ο σίδηρος, το ασβέστιο, το φώσφορο και το μαγνήσιο, μόνο ένα εμπλουτισμένο γάλα μπορεί να του παρέχει όλα αυτά. Εξάλλου, οι περισσότεροι παιδίατροι συμφωνούν ότι οποιοδήποτε άλλο ζωικό γάλα (π.χ. αγελαδινό ή κατσικίσιο) είναι ακατάλληλο μέχρι τον πρώτο χρόνο του μωρού.
Κάπως έτσι, λοιπόν, βρήκα το δικό μου «καλύτερο» για το δικό μου μωρό. Κάπως έτσι ένιωσα λίγη παραπάνω ανακούφιση στη σκέψη ότι, μετά τη μαμά και όσα έχει να του προσφέρει, το μωρό μου θα εισέπραττε την κατάλληλη φροντίδα και αγάπη. Και περίπου έναν χρόνο αργότερα, τώρα που πλέον κοντεύει στα δύο και είναι σχεδόν παιδάκι, ένα καλοθρεμμένο, δυνατό και γεμάτο ενέργεια πιτσιρικάκι, αυτές οι αποφάσεις είναι που με πείθουν πια ότι το καλύτερο για το μωρό σου είναι αυτό που αποδεικνύεται κατάλληλο για τις ανάγκες του.
Sponsored by Nestle Junior